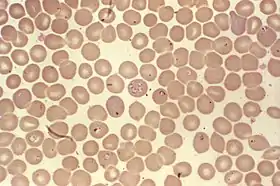

داء البابسيات
البابسيات (بالإنجليزية: Babesiosis) هو مرض يشبه الملاريا ينتقل عن طريق القراد وينتقل عن طريق القراد في خلايا الدم الحمراء[2] .ويدعى أيضاً بداء الكمثريات (داء البابسيات) مرض طفيلي شبيه بالملاريا تسببه اواليات البابيسيا (نسبة إلى مكتشفها الروماني فيكتور بابيس)، ويصيب عادة الحيوانات الداجنة خاصة الكلاب.[3]
| داء البابسيات | |
|---|---|
![]() داء البابسيات | |
| معلومات عامة | |
| الاختصاص | عدوى بداء البابسيات |
| من أنواع | مرض بعدوى الأوليات |
| الأسباب | |
| الأسباب | بابسيا |
| عوامل الخطر | تثبيط مناعي [1]، وطحال [1] |
| المظهر السريري | |
| الأعراض | إعياء ، وغثيان ، وفقدان الشهية ، وتقيؤ ، وألم عضلي ، وصداع ، وحمى ، واضطراب اكتئابي |
| الإدارة | |
| أدوية | |
الأعراض
ومن الممكن أن تكون الأعراض غير واضحة (فلم يتم الإبلاغ عن حدوث طفح جلدي كما يحدث في «داء لايم») وتشمل هذه الأعراض الحمى والرشح والرعشة والصداع والشعور بالتعب وألم العضلات. ومن الممكن أن يشتبه الأطباء في حدوث عدوى «داء البابسيات» إذا كانت الأعراض شديدة أو إذا كانت المضادات الحيوية لا تجدي نفعا. ومن الممكن التأكد من الإصابة عند إجراء فحص الدم. تتميز الاعراض في حمى وتوعك وفقر الدم الإنحلالي. تدمير كريات الدم الحمراء .[5]
العلاج
في الحالات الخفيفة والمتوسطة يعطى بعض الكريمات والادوية مثل مزيج من atovaquone والأزيتروميسين. وايضا الكليندامايسين والكينينالذان لديهم الآثار الجانبية أقل. ويستمر العلاج من 7-10 أيام، ولكن هذا تم تمديده إلى 6 أسابيع على الأقل في الناس برجوع المرض. فمن المستحسن أن يتم التعامل حتى الحالات الخفيفة لتقليل فرصة انتقال العدوى دون عن طريق التبرع بالدم.[6] وفي الحالات والشديدة التي تهدد الحياة، يتم تنفيذ تبديل الدم.[7]
المراجع
- https://www.ncbi.nlm.nih.gov/pmc/articles/PMC4458703/
- Berger, Stephen A.; Marr, John S. (2006). Human Parasitic Diseases Sourcebook. Jones & Bartlett Learning. ISBN 978-0-7637-2962-2. مؤرشف من الأصل في 13 نوفمبر 2013. الوسيط
|CitationClass=تم تجاهله (مساعدة) - Hunfeld KP, Hildebrandt A, Gray JS (2008). "Babesiosis: Recent insights into an ancient disease". Int J Parasitol. 38 (11): 1219–37. doi:10.1016/j.ijpara.2008.03.001. PMID 18440005. الوسيط
|CitationClass=تم تجاهله (مساعدة)صيانة CS1: أسماء متعددة: قائمة المؤلفون (link) - Krause PJ, Telford S, Spielman A; et al. (November 1996). "Comparison of PCR with blood smear and inoculation of small animals for diagnosis of Babesia microti parasitemia" (PDF). J. Clin. Microbiol. 34 (11): 2791–4. PMC 229405. PMID 8897184. مؤرشف من الأصل (PDF) في 28 ديسمبر 2006. الوسيط
|CitationClass=تم تجاهله (مساعدة)صيانة CS1: أسماء متعددة: قائمة المؤلفون (link) - "Neutropenia in congenital and adult babesiosis". Am J Clin Pathol. 144 (1): 94–96. 2015. مؤرشف من الأصل في 18 ديسمبر 2019. الوسيط
|CitationClass=تم تجاهله (مساعدة) - Vannier, Edouard; Krause, Peter J. (21 June 2012). "Human Babesiosis". New England Journal of Medicine. 366 (25): 2397–2407. doi:10.1056/NEJMra1202018. PMID 22716978. الوسيط
|CitationClass=تم تجاهله (مساعدة) - Tanyel, Esra; Guler, Nil; Hokelek, Murat; Ulger, Fatma; Sunbul, Mustafa (2015). "A case of severe babesiosis treated successfully with exchange transfusion". Int J Infect Dis. 38: 83–5. doi:10.1016/j.ijid.2015.07.019. PMID 26232090. الوسيط
|CitationClass=تم تجاهله (مساعدة)
وصلات إضافية
صور وملفات صوتية من كومنز
- Center for Global Health. "Babesiosis". Parasites and Health, DPDx — Laboratory Identification of Parasites of Public Health Concern. Centers for Disease Control & Prevention. مؤرشف من الأصل في 12 ديسمبر 2013. الوسيط
|CitationClass=تم تجاهله (مساعدة) — ملكية عامة source from which the first version of this article was derived. - Homer MJ, Aguilar-Delfin I, Telford SR, Krause PJ, Persing DH (July 2000). "Babesiosis". Clin. Microbiol. Rev. 13 (3): 451–69. doi:10.1128/CMR.13.3.451-469.2000. PMC 88943. PMID 10885987. مؤرشف من الأصل في 03 نوفمبر 2011. الوسيط
|CitationClass=تم تجاهله (مساعدة)صيانة CS1: أسماء متعددة: قائمة المؤلفون (link) - "Babesiosis: Overview" The Merck Veterinary Manual
- Current status of Equine piroplasmosis worldwide at OIE. WAHID Interface - OIE World Animal Health Information Database
- Disease card
- بوابة طب
- بوابة علم الأحياء الدقيقة